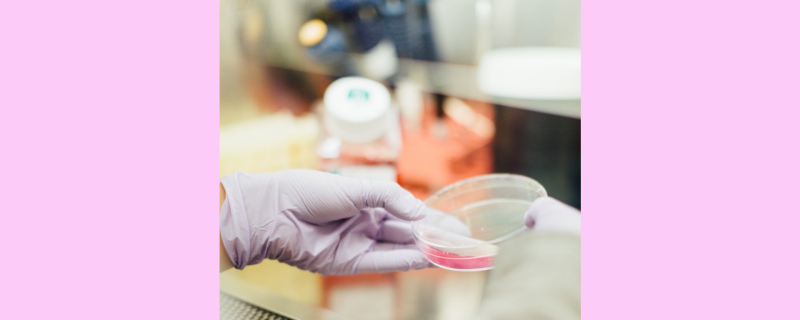

New research reveals that a fundamental process in bacterial gene regulation called sigma cycle, long thought to involve the release of a key protein, sigma factor, might not be universal, opening new avenues for understanding and combating bacterial threats.
A new review reveals that rising global temperatures, increased pollution, and extreme weather events are driving a global surge in eye diseases, disproportionately affecting vulnerable communities and challenging healthcare systems.
Roorkee/